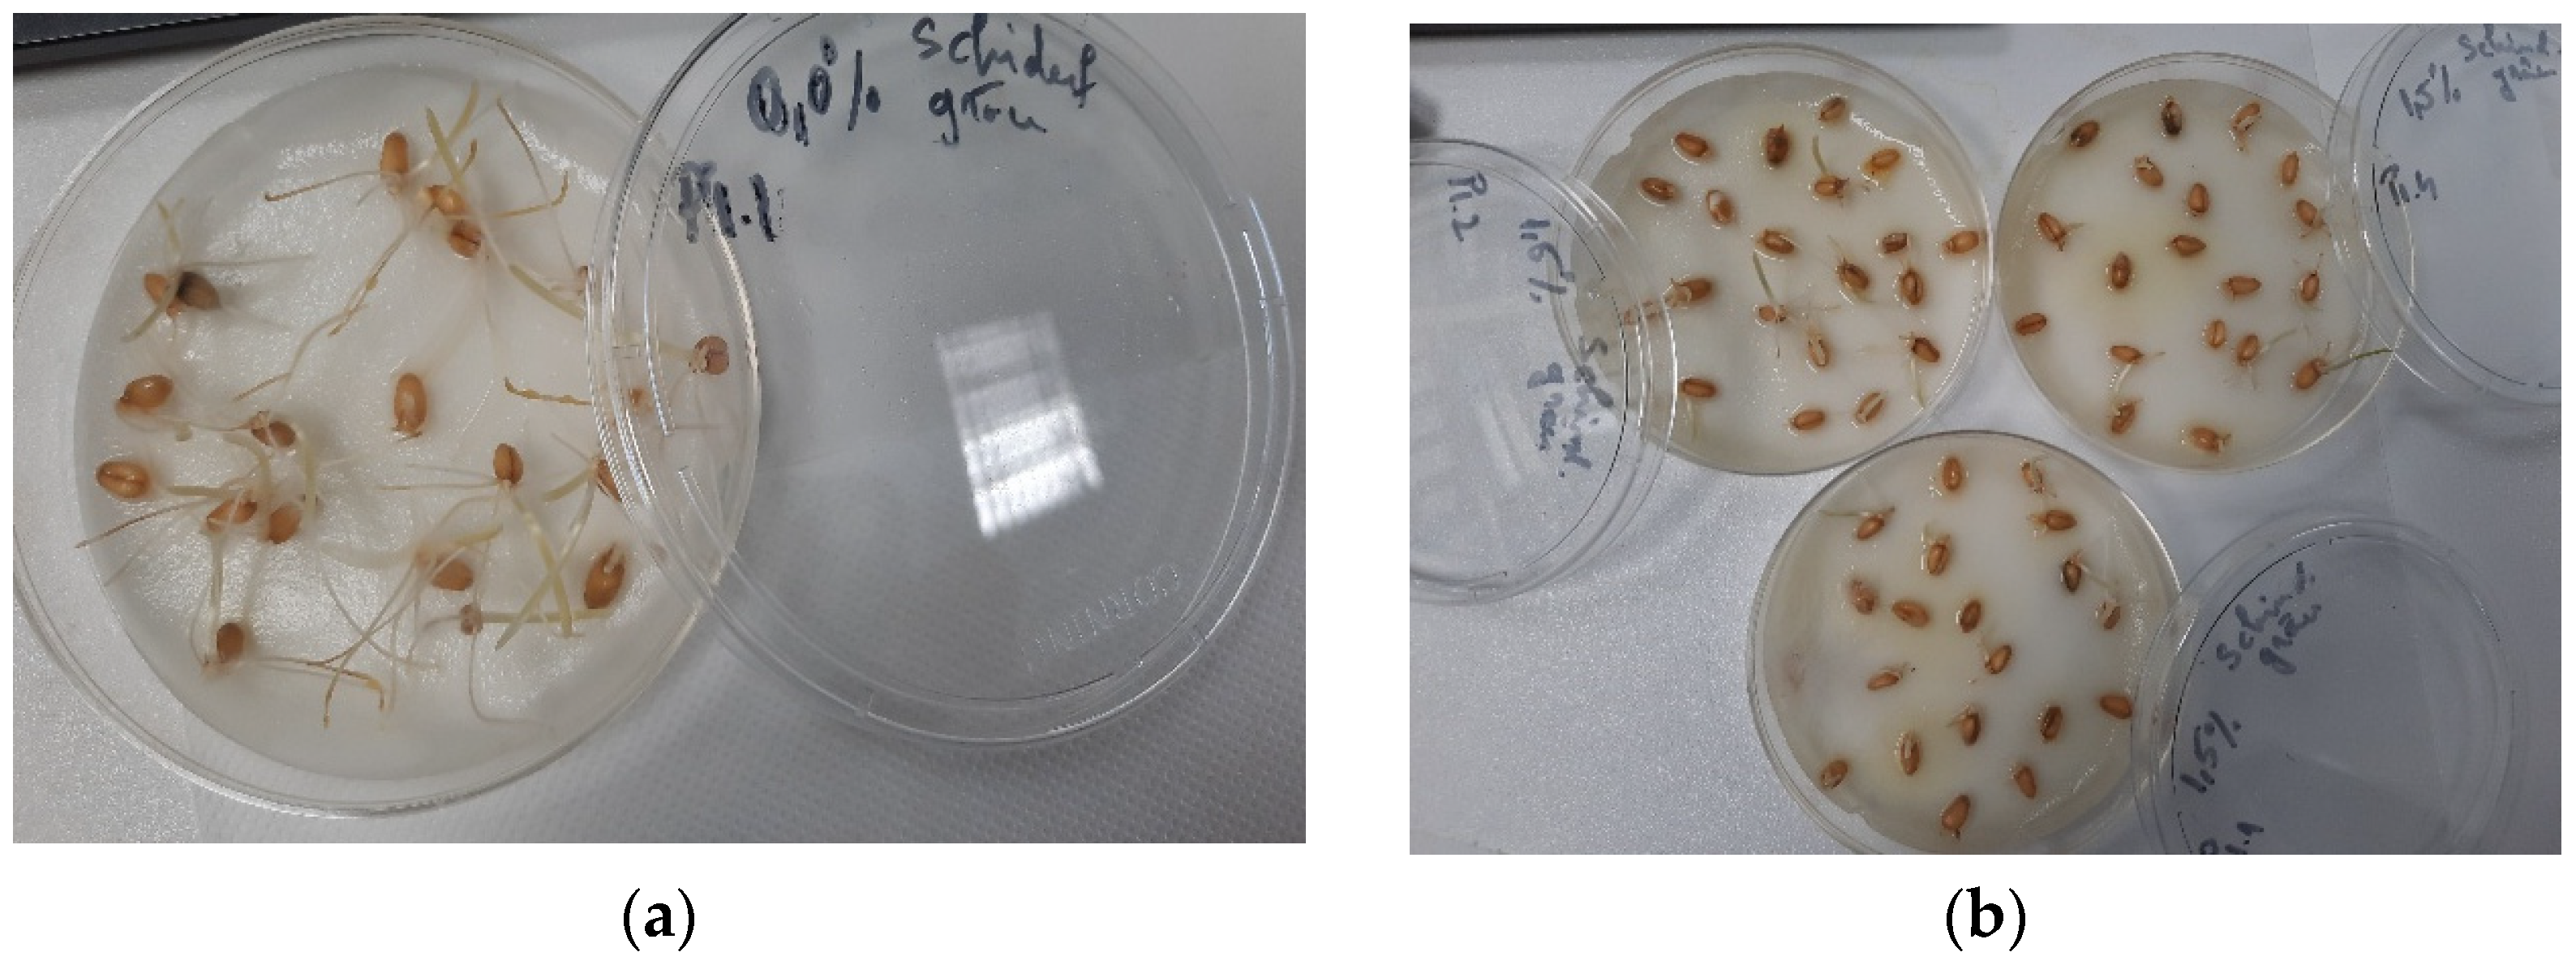
Plants 14 03320 g002 Plants 14 03320 g002

In Vitro Evaluation of the Antifungal Activity of Trigonella foenum-graecum Seed Extract and Its Potential Application in Plant Protection
Abstract
1. Introduction
2. Results and Discussion
2.1. Physico-Chemical Screening of Fenugreek Extract in 40% Ethanol
2.1.1. Spectrum Evaluation by ATR-FT-IR
2.1.2. TPC and TFC Content Dosage
2.1.3. Dosage of Soluble Carbohydrates and Proteins
2.2. Determination of Antioxidant Activity
2.3. The Effect of the Trigonella foenum-graecum Seeds Extract and the Solvent on Wheat Seeds (Triticum Aestivum)
2.4. Trigonella foenum-graecum Seed Extract Antifungal Activity
3. Materials and Methods
3.1. Method of Obtaining the Vegetable Extract and Physicochemical Characterisation
3.2. Qualitative Extract Screening
3.2.1. Highlighting the Presence of Phytochemical Compounds in the Dry Extract of Fenugreek Seeds and Plant Material by the ATR-FT-IR Method
3.2.2. Identification of Bioactive Compounds Using Fourier Transform Ion Cyclotron Resonance High-Resolution Mass Spectrometry (FT-ICR-MS) Analysis
3.2.3. Total Polyphenol Content Dosage—TPC
3.2.4. Total Flavonoid Content—TFC
3.2.5. Determination of Reducing Sugar Content (RSC)
3.2.6. Dosage of Soluble Protein Content
3.3. Antioxidant Activity
3.3.1. Antioxidant Activity by DPPH Method
3.3.2. Antioxidant Activity by the CUPRAC Method
3.3.3. Antioxidant Activity by the FRAP Method
3.3.4. Antioxidant Activity by TEAC (ABTS) Method
3.4. Germination Bioassay
3.5. Catalase, Superoxide Dismutase, Peroxidase, and Lipid Peroxidation Assessment
3.6. Determination of Antifungal Activity
3.6.1. Qualitative Screening of the Antifungal Activity of the 40% Ethanol-Conditioned Extract of Trigonella foenum-graecum L. Seeds Against Some Pathogenic Fungal Species
3.6.2. Quantitative Determination of the Antifungal Activity of the Trigonella foenum-graecum L. Seeds Extract in 40% Ethanol on Some Pathogenic Fungal Species
4. Statistical Analysis
5. Conclusions
Supplementary Materials
Author Contributions
Funding
Institutional Review Board Statement
Data Availability Statement
Acknowledgments
Conflicts of Interest
References
- Youssef, K.; de Oliveira, A.G.; Tischer, C.A.; Hussain, I.; Roberto, S.R. Synergistic Effect of a Novel Chitosan/Silica Nanocomposites-Based Formulation against Gray Mold of Table Grapes and Its Possible Mode of Action. Int. J. Biol. Macromol. 2019, 141, 247–258. [Google Scholar] [CrossRef]
- Hussien, A.; Ahmed, Y.; Al-Essawy, A.H.; Youssef, K. Evaluation of Different Salt-Amended Electrolysed Water to Control Postharvest Moulds of Citrus. Trop. Plant Pathol. 2018, 43, 10–20. [Google Scholar] [CrossRef]
- Porteous-Alvarez, A.J.; Maldonado-González, M.M.; Mayo-Prieto, S.; Lorenzana, A.; Paniagua-García, A.I.; Casquero, P.A. Green Strategies of Powdery Mildew Control in Hop: From Organic Products to Nanoscale Carriers. J. Fungi 2021, 7, 490. [Google Scholar] [CrossRef]
- González-Fernández, R.; Prats, E.; Jorrín-Novo, J.V. Proteomics of Plant Pathogenic Fungi. J. Biomed. Biotechnol. 2010, 2010, 932527. [Google Scholar] [CrossRef] [PubMed]
- El-Baky, N.A.; Amara, A.A.A.F. Recent Approaches towards Control of Fungal Diseases in Plants: An Updated Review. J. Fungi 2021, 7, 900. [Google Scholar] [CrossRef] [PubMed]
- Buttar, Z.A.; Cheng, M.; Wei, P.; Zhang, Z.; Lv, C.; Zhu, C.; Ali, N.F.; Kang, G.; Wang, D.; Zhang, K. Update on the Basic Understanding of Fusarium graminearum Virulence Factors in Common Wheat Research. Plants 2024, 13, 1159. [Google Scholar] [CrossRef]
- Yang, F.; Jacobsen, S.; Jørgensen, H.J.L.; Collinge, D.B.; Svensson, B.; Finnie, C. Fusarium graminearum and Its Interactions with Cereal Heads: Studies in the Proteomics Era. Front. Plant Sci. 2013, 4, 41579. [Google Scholar] [CrossRef] [PubMed]
- Desjardins, A.E.; Proctor, R.H. Molecular Biology of Fusarium Mycotoxins. Int. J. Food Microbiol. 2007, 119, 47–50. [Google Scholar] [CrossRef]
- Balsells-Llauradó, M.; Silva, C.J.; Usall, J.; Vall-llaura, N.; Serrano-Prieto, S.; Teixidó, N.; Mesquida-Pesci, S.D.; de Cal, A.; Blanco-Ulate, B.; Torres, R. Depicting the Battle between Nectarine and Monilinia laxa: The Fruit Developmental Stage Dictates the Effectiveness of the Host Defenses and the Pathogen’s Infection Strategies. Hortic. Res. 2020, 7, 167. [Google Scholar] [CrossRef]
- Bellingeri, M.; Quilot-Turion, B.; Lino, L.O.; Bevacqua, D. The Crop Load Affects Brown Rot Progression in Fruit Orchards: High Fruit Densities Facilitate Fruit Exposure to Spores but Reduce the Infection Rate by Decreasing Fruit Growth and Cuticle Cracking. Front. Ecol. Evol. 2018, 5, 306567. [Google Scholar] [CrossRef]
- Dini, M.; Raseira, M.d.C.B.; Corre, M.N.; Signoret, V.; Quilot-Turion, B. Influence of Fruit Wounding on Subsequent Monilinia laxa Infection of Nectarines. Agronomy 2023, 13, 1235. [Google Scholar] [CrossRef]
- Samson, R.A.; Houbraken, J.; Thrane, U.; Frisvad, J.C.; Andersen, B. Food and Indoor Fungi, 2nd ed.; CBS-KNAW Fungal Biodiversity Centre: Utrecht, The Netherlands, 2010; p. 390. [Google Scholar]
- Ichim, E.; Marutescu, L.; Popa, M.; Cristea, S. Antimicrobial efficacy of some plant extracts on bacterial ring rot pathogen, clavibacter michiganensis ssp. sepedonicus. EuroBiotech J. 2017, 1, 85–88. [Google Scholar] [CrossRef]
- Reshi, Z.A.; Ahmad, W.; Lukatkin, A.S.; Javed, S.B. From Nature to lab: A review of secondary metabolite biosynthetic pathways, environmental influences, and in vitro approaches. Metabolites 2023, 13, 895. [Google Scholar] [CrossRef]
- Ramakrishna, K.; Chakravarthi, G.; Rai, S.; Singh, P.; Mishra, S.; Mishra, D.; Tiwari, N. Biochemical characterization of plant secondary metabolites. In Secondary Metabolites and Biotherapeutics, 1st ed.; Kumar, A., Kumar, S., Eds.; Academic Press: Kolkata, India, 2024; Volume 1, pp. 39–61. [Google Scholar]
- Suteu, D.; Rusu, L.; Zaharia, C.; Badeanu, M.; Daraban, G.M. Challenge of utilization vegetal extracts as natural plant protection products. Appl. Sci. 2020, 10, 8913. [Google Scholar] [CrossRef]
- Deresa, E.M.; Diriba, T.F. Phytochemicals as alternative fungicides for controlling plant diseases: A comprehensive review of their efficacy, commercial representatives, advantages, challenges for adoption, and possible solutions. Heliyon 2023, 9, e13810. [Google Scholar] [CrossRef] [PubMed]
- Zabka, M.; Pavela, R.; Gabrielova-Slezakova, L. Promising antifungal effect of some Euro-Asiatic plants against dangerous pathogenic and toxinogenic fungi. J. Sci. Food Agric. 2011, 91, 492–497. [Google Scholar] [CrossRef] [PubMed]
- Cosoveanu, A.; Cabrera, R.; Giménez Mariño, C.; Iacomi, B.M.; González-Coloma, A. Antifungal activity of plant extracts against pre and postharvest pathogens. Sci. Pap. Ser. A Agon. 2013, LVI, 206–211. [Google Scholar]
- Chon, B.; Xu, S.; Lee, Y.J. Compensation of Strong Water Absorption in Infrared Spectroscopy Reveals the Secondary Structure of Proteins in Dilute Solutions. Anal. Chem. 2021, 93, 2215–2225. [Google Scholar] [CrossRef]
- Barth, A. Infrared Spectroscopy of Proteins. Biochim. Biophys. Acta-Bioenerg. 2007, 1767, 1073–1101. [Google Scholar] [CrossRef]
- Sene, C.F.B.; McCann, M.; Wilson, R.; Grinter, R. Fourier-Transform Raman and Fourier-Transform Infrared Spectroscopy (an Investigation of Five Higher Plant Cell Walls and Their Components). Plant Physiol. 1995, 106, 1623–1631. [Google Scholar] [CrossRef]
- Portaccio, M.; Errico, S.; Chioccarelli, T.; Cobellis, G.; Lepore, M. Fourier-Transform Infrared Microspectroscopy (FT-IR) Study on Caput and Cauda Mouse Spermatozoa. Proceedings 2019, 42, 19. [Google Scholar] [CrossRef]
- El-Bahy, G. FTIR and Raman spectroscopic study of Fenugreek (Trigonella foenum graecum L.) seeds. J. Appl. Spectrosc. 2005, 72, 111–116. [Google Scholar] [CrossRef]
- Akbari, S.; Abdurahman, N.H.; Yunus, R.M.; Fayaz, F. Microwave-assisted extraction of saponin, phenolic and flavonoid compounds from Trigonella foenum-graecum seed based on two level factorial design. J. Appl. Res. Med. Aromat. Plants 2019, 14, 100212. [Google Scholar] [CrossRef]
- Silva, S.D.; Feliciano, R.P.; Boas, L.V.; Bronze, M.R. Application of FTIR-ATR to Moscatel dessert wines for prediction of total phenolic and flavonoid contents and antioxidant capacity. Food Chem. 2014, 150, 489–493. [Google Scholar] [CrossRef] [PubMed]
- Coates, J. Interpretation of infrared spectra: A practical approach. In Encyclopedia of Analytical Chemistry; Meyers, R.A., Ed.; John Wiley and Sons: Chichester, UK, 2006; pp. 1–23. [Google Scholar]
- Houghton, P.J.; Raman, A. Laboratory Handbook for the Fractionation of Natural Extracts. In Laboratory Handbook for the Fractionation of Natural Extracts; Springer Science Business Media: London, UK, 1998; p. 199. [Google Scholar]
- Azmir, J.; Zaidul, I.S.M.; Rahman, M.M.; Sharif, K.M.; Mohamed, A.; Sahena, F.; Omar, A.K.M. Techniques for extraction of bioactive compounds from plant materials: A review. J. Food Eng. 2013, 117, 426–436. [Google Scholar] [CrossRef]
- Chatterjee, S.; Variyar, P.S.; Sharma, A. Effect of γ-irradiation on the antioxidant activity of fenugreek (Trigonella foenum-graecum) seed extract. J. Environ. Agric. Food Chem. 2011, 10, 2798–2805. [Google Scholar]
- Dai, J.; Mumper, R. Plant phenolics: Extraction, analysis and their antioxidant and anticancer properties. Molecules 2010, 15, 7313–7352. [Google Scholar] [CrossRef]
- Rahmani, M.; Hamel, L.; Toumi-Benali, F.; Dif, M.M.; Moume, F.; Rahmani, H. Determination of antioxidant activity, phenolic quantification of four varieties of fenugreek Trigonella foenum graecum L. seed extract cultured in west Algeria. J. Mater. Environ. Sci. 2018, 9, 1656–1661. [Google Scholar]
- Turker, I.; Dastan, S.; Isleroglu, H. Extraction of phenolic compounds from fenugreek seeds using different extraction techniques. In Proceedings of the III. International Agricultural, Biological & Life Science Conference, Edirne, Turkey, 1–3 September 2021. [Google Scholar]
- Lohvina, H.; Sándor, M.; Wink, M. Effect of ethanol solvents on total phenolic content and antioxidant properties of seed extracts of fenugreek (Trigonella foenum-graecum L.) varieties and determination of phenolic composition by HPLC-ESI-MS. Diversity 2021, 14, 7. [Google Scholar] [CrossRef]
- Jokic, S.; Bucić-Kojić, A.; Planinić, M.; Velić, D.; Tomas, S.; Bilic, M.; Bešvir, Ž. The effect of solvent and temperature on extraction yield of phenolic compounds from soybeans, antioxidant activity and colour of extracts. In Proceedings of the 5th International Congress FLOUR-BREAD ’09, 7th Croatian Congress of Cereal Technologists, Opatja, Croatia, 21–23 October 2009. [Google Scholar]
- Norziah, M.H.; Fezea, F.A.; Bhat, R.; Ahmad, M. Effect of extraction solvents on antioxidant and antimicrobial properties of fenugreek seeds (Trigonella foenum-graecum L.). Int. Food Res. J. 2015, 22, 1261–1271. [Google Scholar]
- Amid, B.T.; Mirhosseini, H. Effect of different purification techniques on the characteristics of heteropolysaccharide-protein biopolymer from durian (Durio zibethinus) seed. Molecules 2012, 17, 10875–10892. [Google Scholar] [CrossRef] [PubMed]
- Kaczorová, D.; Karalija, E.; Dahija, S.; Bešta-Gajević, R.; Parić, A.; Ćavar Zeljković, S. Influence of Extraction Solvent on the Phenolic Profile and Bioactivity of Two Achillea Species. Molecules 2021, 26, 1601. [Google Scholar] [CrossRef]
- Rivas-García, L.; Crespo-Antolín, L.; Forbes-Hernández, T.Y.; Romero-Márquez, J.M.; Navarro-Hortal, M.D.; Arredondo, M.; Llopis, J.; Quiles, J.L.; Sánchez-González, C. Bioactive Properties of Tagetes erecta Edible Flowers: Polyphenol and Antioxidant Characterization and Therapeutic Activity against Ovarian Tumoral Cells and Caenorhabditis elegans Tauopathy. Int. J. Mol. Sci. 2024, 25, 280. [Google Scholar] [CrossRef] [PubMed]
- Syed, Q.A.; Rashid, Z.; Ahmad, M.H.; Shukat, R.; Ishaq, A.; Muhammad, N.; Rahman, H.U.U. Nutritional and therapeutic properties of fenugreek (Trigonella foenum-graecum): A review. Int. J. Food Prop. 2020, 23, 1777–1791. [Google Scholar] [CrossRef]
- Yilmaz, Y.; Toledo, R.T. Oxygen radical absorbance capacities of grape/-wine industry byproducts and effect of solvent type on the extraction of grape seed polyphenols. J. Food Compos. Anal. 2006, 19, 8. [Google Scholar] [CrossRef]
- Premanath, R.; Sudisha, N.; Devi, N.L.; Aradhya, S.M. Antibacterial and anti-oxidant activities of fenugreek (Trigonella foenum graecum L.) leaves. Res. J. Med. Plant 2011, 5, 695–705. [Google Scholar] [CrossRef]
- Sudina, G.F.; Mirzoeva, O.K.; Pushkarevr, M.A.; Korshunova, G.; Sumbatyan, N.V.; Varfolomeev, S.D. Caffeic acid phenethyl ester as a lipoxygenase inhibitor with antioxidant properties. FEBS Lett. 1993, 329, 21–24. [Google Scholar] [CrossRef]
- Sakhria, M.; Hichem, A.; Hafsia, B.; Abdelfettah, E.; Najla, H. Phytochemical study and protective effect of Trigonella foenum-graecum (Fenugreek seeds) against carbon tetrachloride-induced toxicity in liver and kidney of male rat. Biomed. Pharmacother. 2016, 88, 19–26. [Google Scholar]
- Pasha, I.; Shabbir, M.A.; Haider, M.A.; Afzal, B.; Chughtai, M.F.; Ahmad, S.; Manzoor, M.S. Biochemical Evaluation of Trigonella foenum graecum (Fenugreek) with Special Reference to Phenolic Acids. Pak. J. Sci. Ind. Res. Ser. B Biol. Sci. 2017, 60, 154–161. [Google Scholar]
- Singh, P.; Bajpai, V.; Gond, V.; Kumar, A.; Tadigoppula, N.; Kumar, B. Determination of Bioactive Compounds of Fenugreek (Trigonella foenum-graecum) Seeds Using LC-MS Techniques. Mol. Biol. 2020, 2107, 377–393. [Google Scholar]
- Bandara, K.R.V.; Padumadasa, C.; Peiris, D.C. Potent antibacterial, antioxidant and toxic activities of extracts from Passiflora suberosa L. leaves. PeerJ Life Environ. 2018, 6, e4804. [Google Scholar] [CrossRef] [PubMed]
- Amborabé, B.-E.; Fleurat-Lessard, P.; Chollet, J.-F.; Roblin, G. Antifungal effects of salicylic acid and other benzoic acid derivatives towards Eutypa lata: Structure–activity relationship. Plant Phys. Biochem. 2002, 40, 1051–1060. [Google Scholar] [CrossRef]
- Hernández-Guzmán, C.; Hernández-Montiel, L.G.; Velázquez-Lizarraga, A.E.; Ríos-González, L.J.; Huerta-Ochoa, S.; Cervantes-Güicho, V.d.J.; Morales-Martínez, T.K.; Mejía-Ruíz, C.H.; Reyes, A.G. Improved antioxidant, antifungal and herbicidal activities through the bioconversion of diosgenin by Yarrowia lipolytica P01a. Plants 2024, 13, 2629. [Google Scholar] [CrossRef]
- Haouala, R.; Hawala, S.; El-Ayeb, A.; Khanfir, R.; Boughanmi, N. Aqueous and organic extracts of Trigonella foenum-graecum L. inhibit the mycelia growth of fungi. J. Environ. Sci. 2008, 20, 1453–1457. [Google Scholar] [CrossRef]
- Khatri, D.; Chhetri, S.B.B. Reducing Sugar, Total Phenolic Content, and Antioxidant Potential of Nepalese Plants. BioMed Res. Int. 2020, 2020, 7296859. [Google Scholar] [CrossRef]
- Dawood, M.G.; El-Rorkiek, K.G.A.; El-Awadi, M.E.-S.; Sadak, M.S. Physiological effect of aqueous seed extract of fenugreek on productivity and grain quality of wheat plant. Asian J. Appl. Sci. 2020, 13, 107–113. [Google Scholar] [CrossRef]
- Jeandet, P.; Formela-Luboińska, M.; Labudda, M.; Morkunas, I. The Role of Sugars in Plant Responses to Stress and Their Regulatory Function during Development. Int. J. Mol. Sci. 2022, 23, 5161. [Google Scholar] [CrossRef]
- Patel, J.; Dhruve, J.; Talati, J. Nutraceutical and molecular characterization of different fenugreek (Trigonella foenum-graecum L.) genotypes. World J. Pharm. Pharm. Sci. 2015, 4, 1267–1287. [Google Scholar]
- Ghevariya, H.; Vatukiya, V.; Mistry, N.; JJain, N. Comparative evaluation of bioactive compounds and antioxidant properties of fenugreek (Trigonella foenum-graecum L.) seed, stem, leaf, and microgreens. Third Concept Int. J. Ideas 2023, 37, 62–75. [Google Scholar]
- Valko, M.; Leibfritz, D.; Moncol, J.; Cronin, M.T.D.; Mazur, M.; Telser, J. Free radicals and antioxidants in normal physiological functions and human disease. Int. J. Biochem. Cell Biol. 2007, 39, 44–84. [Google Scholar] [CrossRef] [PubMed]
- Radi, R. Oxygen radicals, nitric oxide, and peroxynitrite: Redox pathways in molecular medicine. PNAS J. 2018, 115, 5839–5848. [Google Scholar] [CrossRef] [PubMed]
- Sies, H.; Jones, D.P. Reactive oxygen species (ROS) as pleiotropic physiological signalling agents. Nat. Rev. Mol. Cell Biol. 2020, 21, 363–383. [Google Scholar] [CrossRef] [PubMed]
- Murphy, M.P. How mitochondria produce reactive oxygen species. Biochem J. 2009, 417, 1–13. [Google Scholar] [CrossRef]
- Turrens, J.F. Mitochondrial formation of reactive oxygen species. J. Physiol. 2003, 552, 335–344. [Google Scholar] [CrossRef]
- Bahorun, T.; Soobrattee, M.A.; Luximon-Ramma, V.; Aruoma, O.I. Free radicals and antioxidants in cardiovascular health and disease. Internet J. Med. Update 2006, 1, 25–41. [Google Scholar] [CrossRef]
- Butterfield, D.A. Amyloid beta-peptide (1-42)-induced oxidative stress and neurotoxicity: Implications for neurodegeneration in Alzheimer’s disease brain. A review. Free Radic. Res. 2002, 36, 1307–1313. [Google Scholar] [CrossRef]
- Mahajan, A.; Tandon, V.R. Antioxidants and rheumatoid arthritis. J. Indian Rheumatol. Ass. 2004, 12, 139–142. [Google Scholar]
- Meyer, C.H.; Sekundo, W. Nutritional supplementation to prevent cataract formation. Dev. Ophthalmol. 2005, 38, 103–119. [Google Scholar] [PubMed]
- Hracsko, Z.; Orvos, H.; Novak, Z.; Pal, A.; Varga, I.S. Evaluation of oxidative stress markers in neonates with intra-uterine growth retardation. Redox. Rep. 2008, 13, 11–16. [Google Scholar] [CrossRef]
- Manjamalai, A.; Berlin Grace, V.M. Antioxidant activity of essential oils from Wedelia chinensis (osbeck) in vitro and in vivo lung cancer bearing C57BL/6 mice. Asian Pac. J. Cancer Prev. 2012, 13, 3065–3071. [Google Scholar] [CrossRef]
- Bari, M.W.; Islam, A.; Islam, M.M.; Sultana, M.J.; Afroz, R.; Khan, M.M.R.; Parul, S.S.; Swaraz, A.M.; Hossain, M.I.; Islam, M.A. Determination of in vitro antioxidant activity and in vivo antineoplastic effects against Ehrlich ascites carcinoma of methanolic extract of Sphagneticola calendulacea (L.) Pruski. Heliyon 2021, 7, e07228. [Google Scholar] [CrossRef]
- Lee, K.J.; Oh, Y.C.; Cho, W.K.; Ma, J.Y. Antioxidant and Anti-Inflammatory Activity Determination of One Hundred Kinds of Pure Chemical Compounds Using Offline and Online Screening HPLC Assay. Evid.-Based Complement. Altern. Med. 2015, 2015, 165457. [Google Scholar] [CrossRef]
- Floegel, A.; Kim, D.; Chung, S.; Koo, S.I.; Chun, O.K. Comparison of ABTS/DPPH assays to measure antioxidant capacity in popular antioxidant-rich US foods. J. Food Compos. Anal. 2011, 24, 1043–1048. [Google Scholar] [CrossRef]
- Kaya, E.; Akbas, P. Determination of the Antimicrobial, Antioxidant Activities and Fatty Acid Composition of Peganum harmala Seed. Braz. Arch. Biol. Tech. 2022, 66, e23220237. [Google Scholar]
- Bukhari, S.B.; Bhanger, M.I.; Memon, S. Antioxidative Activity of Extracts from Fenugreek Seeds (Trigonella foenum-graecum). Pak. J. Anal. Environ. Chem. 2008, 9, 78–83. [Google Scholar]
- Mitelut, A.C.; Popa, M.E. Seed germination bioassay for toxicity evaluation of different composting biodegradable materials. Rom. Biotechnol. Lett. 2011, 16, 12–129. [Google Scholar]
- Zucconi, F.; Monaco, A.; Forte, M.; Bertoldi, M. Phytotoxins during the stabilization of organic matter. In Composting of Agricultural and Other Wastes; Gasser, J.K.R., Ed.; Elsevier Applied Science: London, UK; New York, NY, USA, 1985; pp. 73–88. [Google Scholar]
- Handreck, K.; Black, N. Growing Media for Ornamental Plants and Turfs, 3rd ed.; Wales University Press: Kensington, NSW, Australia, 2002; pp. 136–151. [Google Scholar]
- Oncel, I.; Keles, Y.; Ustun, A.S. Interactive effects of temperature and heavy metal stress on the growth and some biochemical compounds in wheat seedlings. Environm. Pollut. 2000, 107, 315–320. [Google Scholar] [CrossRef]
- Ravindran, B.; Mupambwa, H.A.; Silwana, S.; Mnkeni, P.N.S. Assessment of Nutrient Quality, Heavy Metal and Phytotoxic Properties of Chicken Manure on Selected Commercial Vegetable Crops. Heliyon 2017, 3, e00493. [Google Scholar] [CrossRef]
- Araujo, A.S.F.; Monteiro, R.T.R. Plant bioassays to assess the toxicity of textile sludge compost. Sci. Agri. 2005, 62, 286–290. [Google Scholar] [CrossRef]
- Emino, E.R.; Warman, P.R. Biological Assay for Compost Quality. Compost. Sci. Util. 2004, 12, 342–348. [Google Scholar] [CrossRef]
- Luo, Y.; Liang, J.; Zeng, G.; Mo, D.; Li, G.; Zhang, D. Seed germination test for toxicity evaluation of compost: Its roles, problems and prospects. Waste Manag. 2018, 71, 109–114. [Google Scholar] [CrossRef]
- Haugland, E.; Brandsaeter, L.O. Experiments on bioassay sensitivity in the study of allelopathy. J. Chem. Ecol. 1996, 22, 1845–1859. [Google Scholar] [CrossRef]
- Hoffman, M.L.; Weston, L.A.; Snyder, J.C.; Regnier, E.E. Allelopathic influence of germinating seeds and seedlings of cover crops on weed species. Weed Sci. 1996, 44, 579–584. [Google Scholar] [CrossRef]
- Mominul Islam, A.K.M.; Kato-Noguchi, H. Phytotoxic Activity of Ocimum tenuiflorum Extracts on Germination and Seedling Growth of Different Plant Species. Sci. World J. 2014, 2014, 676242. [Google Scholar] [CrossRef]
- Azizi, G.; Kondori, M.J.; Siah-Marguee, A.; Alimoradi, L. Bioassay study of fenugreek extract’s allelopathic effects on thegermination and growth of several crops and weeds. J. Plant Breed. Crop. Sci. 2011, 3, 229–239. [Google Scholar]
- Leather, G.R.; Einhellig, F.A. Bioassay of naturally occurring allelochemicals for toxicity. J. Chem. Ecol. 1988, 14, 1821–1828. [Google Scholar] [CrossRef] [PubMed]
- Xuan, T.D.; Tsuzuki, E.; Hiroyuki, T.; Mitsuhiro, M.; Khanh, T.D.; Chung, I.M. Evaluationon phytotoxicity of neem (Azadirachta indica. A. Juss) to crops and weeds. Crop Prot. 2004, 23, 335–345. [Google Scholar] [CrossRef]
- Fuentes, A.; Llorens, M.; Saez, J.; Aguilar, M.I.; Ortuno, J.F.; Meseguer, V.F. Phytotoxicity and heavy metals speciation of stabilised sewage sludges. J. Hazard. Mater. 2004, 108, 161–169. [Google Scholar] [CrossRef]
- Roy, S.; Asaduzzaman, M.; Pramanik, H.; Prodhan, K. Effect of banana plant extracts on germination and seedling growth of some vegetable crops. Bangladesh J. Crop Sci. 2006, 17, 235–242. [Google Scholar]
- Cesaro, A.; Belgiorno, V.; Guida, M. Compost from organic solid waste: Quality assessment and European regulations for its sustainable use. Resour. Conserv. Recycl. 2015, 94, 72–79. [Google Scholar] [CrossRef]
- Reigosa, M.J.; Souto, X.C.; Gonzalez, L. Effect of phenolic compounds on the germination of six weeds species. Plant Growth Regul. 1999, 28, 83–88. [Google Scholar] [CrossRef]
- Dai, L.; Wu, L.; Zhou, X.; Jian, Z.; Meng, L.; Xu, G. Effects of water extracts of Flaveria bidentis on the seed germination and seedling growth of three plants. Sci. Rep. 2022, 12, 17700. [Google Scholar] [CrossRef]
- Kucera, B.; Cohn, M.A.; Leubner-Metzger, G. Plant hormone interactions during seed dormancy release and germination. Seed Sci. Res. 2005, 15, 281–307. [Google Scholar] [CrossRef]
- El-Maarouf-Bouteau, H.; Sajjad, Y.; Bazin, J.; Langlade, N.; Cristescu, S.M.; Balzergue, S.; Baudouin, E.; Bailly, C. Reactive oxygen species, abscisic acid and ethylene interact to regulate sunflower seed germination. Plant Cell Environ. 2015, 38, 364–374. [Google Scholar] [CrossRef]
- Ma, Z.; Marsolais, F.; Bykova, N.V.; Igamberdiev, A.U. Nitric Oxide and Reactive Oxygen Species Mediate Metabolic Changes in Barley Seed Embryo during Germination. Front. Plant Sci. 2016, 7, 138. [Google Scholar] [CrossRef]
- Park, M.R.; Hasenstein, K.H. Oxygen dependency of germinating Brassica seeds. Life Sci. Space Res. 2016, 8, 30–37. [Google Scholar] [CrossRef]
- Doria, E.; Pagano, A.; Ferreri, C.; Larocca, A.V.; Macovei, A.; Araújo, S.d.S.; Balestrazzi, A. How does the seed pre-germinative metabolism fight against imbibition damage? Emerging roles of fatty acid cohort and antioxidant defence. Front. Plant Sci. 2019, 10, 1505. [Google Scholar] [CrossRef] [PubMed]
- Gomes, P.M.; Garcia, Q.S. Reactive oxygen species and seed germination. Biologia 2013, 68, 351–357. [Google Scholar] [CrossRef]
- Del Río, L.A.; Sandalio, L.M.; Palma, J.M.; Bueno, P.; Corpas, F.J. Reactive oxygen species and reactive nitrogen species in peroxisomes. Production, scavenging, and role in cell signaling. Plant Physiol. 2006, 141, 330–335. [Google Scholar] [CrossRef]
- Gill, S.S.; Tuteja, N. Reactive oxygen species and antioxidant machinery in abiotic stress tolerance in crop plants. Plant Physiol. Biochem. 2010, 48, 909–930. [Google Scholar] [CrossRef] [PubMed]
- Mittler, R. Oxidative stress, antioxidants and stress tolerance. Trends Plant Sci. 2002, 7, 405–410. [Google Scholar] [CrossRef]
- Apel, K.; Hirt, H. Reactive oxygen species: Metabolism, oxidative stress, and signal transduction. Annu. Rev. Plant Biol. 2004, 55, 373–399. [Google Scholar] [CrossRef] [PubMed]
- Hasanuzzaman, M.; Hossain, M.A.; Fujita, M. Plant responses and tolerance to abiotic oxidative stress: Antioxidant defenses is a key factor. HERO J. 2012, 261–315. [Google Scholar]
- Kulkarni, M.; Hastak, V.; Jadhav, V.; Date, A.A. Fenugreek Leaf Extract and Its Gel Formulation Show Activity Against Malassezia Furfur. Assay Drug Dev. Technol. 2020, 18, 45–55. [Google Scholar] [CrossRef]
- Tan, L.F.; Yap, V.L.; Rajagopal, M.; Wiart, C.; Selvaraja, M.; Leong, M.Y.; Tan, P.L. Plant as an Alternative Source of Antifungals against Aspergillus Infections: A Review. Plants 2022, 11, 3009. [Google Scholar] [CrossRef]
- lvarez-García, S.; Moumni, M.; Romanazzi, G. Antifungal Activity of Volatile Organic Compounds from Essential Oils against the Postharvest Pathogens Botrytis cinerea, Monilinia fructicola, Monilinia fructigena, and Monilinia laxa. Front. Plant Sci. 2023, 14, 1274770. [Google Scholar] [CrossRef]
- Oerke, E.C.; Dehne, H.W. Safeguarding Production-Losses in Major Crops and the Role of Crop Protection. Crop Prot. 2004, 23, 275–285. [Google Scholar] [CrossRef]
- Pétriacq, P.; López, A.; Luna, E. Fruit Decay to Diseases: Can Induced Resistance and Priming Help? Plants 2018, 7, 77. [Google Scholar] [CrossRef]
- Cizmarova, B.; Hubkova, B.; Bolerazska, B.; Marekova, M.; Birková, A. Caffeic acid: A brief overview of its presence, metabolism, and bioactivity. Bioact. Compd. Health Dis. 2020, 3, 74–81. [Google Scholar]
- Ingole, A.S.; Kadam, M.; Dalu, A.P.; Kute, S.M.; Mange, P.R.; Theng, V.; Lahane, O.R.; Nikas, A.P.; Kawal, Y.V.; Nagrik, S.U.; et al. A Review of the Pharmacological Characteristics of Vanillic Acid. J. Drug Deliv. Ther. 2021, 11, 200–204. [Google Scholar] [CrossRef]
- Anand David, A.V.; Arulmoli, R.; Parasuraman, S. Overviews of Biological Importance of Quercetin: A Bioactive Flavonoid. Pharmacogn. Rev. 2016, 10, 84–89. [Google Scholar] [CrossRef]
- Pyrzynska, K. Hesperidin: A Review on Extraction Methods, Stability and Biological Activities. Nutrients 2022, 14, 2387. [Google Scholar] [CrossRef]
- Shakeel, A.; Jewel, J.N.; Uzma, J.; Aabida, G.; Zafar, H.; Nasheeman, A. Saponins, the Unexplored Secondary Metabolites in Plant Defense: Opportunities in Integrated Pest Management. Plants 2025, 14, 861. [Google Scholar] [CrossRef]
- Abdelrahman, M.; Sudisha, J. Saponins Versus Plant Fungal Pathogens. Bioact. Mol. Plant Def. 2020, 37–45. [Google Scholar] [CrossRef]
- Cho, J.; Hyemin Choi, J.; Lee, M.S.K.; Ho, Y.S.; Dong, G. The Antifungal Activity and Membrane-Disruptive Action of Dioscin Extracted from Dioscorea Nipponica. BBA Biomembr. 2013, 1828, 1153–1158. [Google Scholar] [CrossRef] [PubMed]
- Chapagain, B.P.; Zeev, W.; Leah, T. In Vitro Study of the Antifungal Activity of Saponin-Rich Extracts against Prevalent Phytopathogenic Fungi. Ind. Crops Prod. 2007, 26, 109–115. [Google Scholar] [CrossRef]
- Nguyen, D.H.; Vo, T.N.N.; Le, N.T.T.; Thi, D.P.N.; Thi, T.T.H. Evaluation of Saponin-Rich/Poor Leaf Extract-Mediated Silver Nanoparticles and Their Antifungal Capacity. Green Process. Synth. 2020, 9, 429–439. [Google Scholar] [CrossRef]
- Castano-Duque, L.; Lebar, M.D.; Mack, B.M.; Lohmar, J.M.; Carter-Wientjes, C. Investigating the Impact of Flavonoids on Aspergillus Flavus: Insights into Cell Wall Damage and Biofilms. J. Fungi 2024, 10, 665. [Google Scholar] [CrossRef]
- Dembińska, K.; Ambika, H.S.; Pejchalová, M.; Richert, A.; Swiontek, B.M. The Application of Natural Phenolic Substances as Antimicrobial Agents in Agriculture and Food Industry. Foods 2025, 14, 1893. [Google Scholar] [CrossRef]
- Trang, T.-M.; Ponts, N.; Bernillon, S.; Waffo-Téguo, P.; Rouger, C.; Richard-Forget, F.; Atanasova, V. Integrated Metabolomic and Transcriptomic Analysis to Elucidate the Antifungal and Antimycotoxin Mechanisms of Natural Stilbenoids against Fusarium graminearum. Microbiol. Res. 2025, 128370. [Google Scholar] [CrossRef]
- Kamaldeep, C.; Hausner, G.; Harris, S.D. Regulation of Melanin Production in Fungi. Front. Fungal Biol. 2025, 6, 1621764. [Google Scholar] [CrossRef] [PubMed]
- Rodríguez-Pires, S.; Melgarejo, P.; De Cal, A.; Espeso, E.A. Proteomic Studies to Understand the Mechanisms of Peach Tissue Degradation by Monilinia laxa. Front. Plant Sci. 2020, 11, 569243. [Google Scholar] [CrossRef] [PubMed]
- Perisoara, A.; Marinas, I.C.; Geana, E.I.; Constantin, M.; Angheloiu, M.; Pirvu, L.; Cristea, S. Phytostimulation and Synergistic Antipathogenic Effect of Tagetes erecta Extract in Presence of Rhizobacteria. Horticulturae 2022, 8, 779. [Google Scholar] [CrossRef]
- Singleton, V.L.; Orthofer, R.; Lamuela-Raventós, R.M. Analysis of Total Phenols and Other Oxidation Substrates and Antioxidants by Means of Folin-Ciocalteu Reagent. Methods Enzymol. 1999, 299, 152–178. [Google Scholar]
- Formagio, A.S.N.; Kassuya, C.A.L.; Neto, F.F.; Volobuff, C.R.F.; Iriguchi, E.K.K.; Vieira, M.d.C.; Foglio, M.A. The Flavonoid Content and Antiproliferative, Hypoglycaemic, Anti-Inflammatory and Free Radical Scavenging Activities of Annona dioica St. Hill. BMC Complement. Altern. Med. 2013, 13, 14. [Google Scholar] [CrossRef]
- Bradford, M.M. A rapid and sensitive method for the quantitation of microgram quantities of protein utilizing the principle of protein-dye binding. Anal. Biochem. 1976, 72, 248–254. [Google Scholar] [CrossRef] [PubMed]
- Lorca, M.; Vega-Muñoz, A.; Acosta, A.; Cabezas, D.; Díaz, K.; Mella, J.; Sabadini, G.; Salazar-Sepúlveda, G.; Contreras-Barraza, N.; Mellado, M. Past and Present of the Antioxidant Studies in Chile: A Bibliometric Study from 2000 to 2024. Antioxidants 2025, 14, 985. [Google Scholar] [CrossRef]
- Knez, E.; Kadac-Czapska, K.; Grembecka, M. Evaluation of Spectrophotometric Methods for Assessing Antioxidant Potential in Plant Food Samples—A Critical Approach. Appl. Sci. 2025, 15, 5925. [Google Scholar] [CrossRef]
- Huang, D.; Ou, B.; Prior, R.L. The chemistry behind antioxidant capacity assays. J. Agric. Food Chem. 2005, 53, 1841–1856. [Google Scholar] [CrossRef]
- Kotha, R.R.; Tareq, F.S.; Yildiz, E.; Luthria, D.L. Oxidative Stress and Antioxidants—A Critical Review on In Vitro Antioxidant Assays. Antioxidants 2022, 11, 2388. [Google Scholar] [CrossRef]
- Tumilaar, S.G.; Hardianto, A.; Dohi, H.; Kurnia, D. A Comprehensive Review of Free Radicals, Oxidative Stress, and Antioxidants: Overview, Clinical Applications, Global Perspectives, Future Directions, and Mechanisms of Antioxidant Activity of Flavonoid Compounds. J. Chem. 2024, 5594386. [Google Scholar] [CrossRef]
- Blois, M.S. Antioxidant determinations by the use of a stable free radical. Nature 1958, 181, 1199–1200. [Google Scholar] [CrossRef]
- Mishra, K.; Ojha, H.; Chaudhury, N.K. Estimation of antioxidant activity of plant extracts using DPPH assay: A review. Free. Radic. Antioxid. 2012, 2, 24–30. [Google Scholar]
- Prior, R.L.; Wu, X.; Schaich, K. Standardized methods for the determination of antioxidant capacity and phenolics in foods and dietary supplements. J. Agric. Food Chem. 2005, 53, 4290–4302. [Google Scholar] [CrossRef] [PubMed]
- Madhu, G.; Bose, V.C.; Aiswaryaraj, A.S.; Maniammal, K.; Biju, V. Defect Dependent Antioxidant Activity of Nanostructured Nickel Oxide Synthesized through a Novel Chemical Method. Colloids Surf. A Physicochem. Eng. Asp. 2013, 429, 44–50. [Google Scholar] [CrossRef]
- Çelik, S.E.; Özyürek, M.; Güçlü, K.; Apak, R. Determination of Antioxidants by a Novel On-Line HPLC-Cupric Reducing Antioxidant Capacity (CUPRAC) Assay with Post-Column Detection. Anal. Chim. Acta 2010, 674, 79–88. [Google Scholar] [CrossRef] [PubMed]
- Corbu, V.M.; Gheorghe, I.; Marinaș, I.C.; Geană, E.I.; Moza, M.I.; Csutak, O.; Chifiriuc, M.C. Demonstration of Allium sativum Extract Inhibitory Effect on Biodeteriogenic Microbial Strain Growth, Biofilm Development, and Enzymatic and Organic Acid Production. Molecules 2021, 26, 7195. [Google Scholar] [CrossRef]
- Thaipong, K.; Boonprakob, U.; Crosby, K.; Cisneros-Zevallos, L.; Hawkins Byrne, D. Comparison of ABTS, DPPH, FRAP, and ORAC Assays for Estimating Antioxidant Activity from Guava Fruit Extracts. J. Food Compos. Anal. 2006, 19, 669–675. [Google Scholar] [CrossRef]
- Ghayal, N.; Biware, M.; Gharpure, P. Phytotoxic Effects of Leaf Leachates of Invasive Weeds Cosmos sulphureus and Xanthium strumarium on Agricultural Crops. Biosci. Biotechnol. Res. ASIA 2018, 15, 821–832. [Google Scholar] [CrossRef]
- Perişoară, A.; Pîrvu, L.; Ene, D.M.; Pavel, M.; Olariu, L.; Cristea, S. The influence of two types of extracts obtained from Tagetes erecta flowers on radish seeds. Sci. Pap. Ser. B Hortic. 2024, 68, 486. [Google Scholar]
- Milon, A.R.; Chang, S.W.; Ravindran, B. Biochar amended compost maturity evaluation using commercial vegetable crops seedlings through phytotoxicity germination bioassay. J. King Saud Univ. Sci. 2022, 34, 101770. [Google Scholar] [CrossRef]
- EPA. Ecological Effects Test Guidelines OPPTS 850.4200, Seed Germination/Root Elongation Toxicity Test; EPA: Washington, DC, USA, 1996.
- Alamri, S.; Siddiqui, M.; Al-Khaiskani, M.; Ali, H. Response of salicylic acid on seed germination and physio-biochemical 587 changes of wheat under salt stress. Acta Sci. Agric. 2018, 2, 36–42. [Google Scholar]
- Kaya, M.; Okçu, G.; Atak, M.; Çikili, Y.; Kolsarici, Ö. Seed treatments to overcome salt and drought stress during germination in sunflower (Helianthus annuus L.). EJA 2006, 24, 291–295. [Google Scholar] [CrossRef]
- Aebi, H. Catalase in vitro. Methods Enzymol. 1984, 105, 121–126. [Google Scholar]
- McCord, J.M.; Fridovich, I. Superoxide dismutase: An enzymic function for erythrocuprein (hemocuprein). J. Biol. Chem 1969, 244, 6049–6055. [Google Scholar] [CrossRef] [PubMed]
- Prochazkova, D.; Wilhelmová, N.; Vysloužilová, M. Antioxidant enzyme activities in relation to stress resistance of plants. Biol. Plant 2001, 44, 345–350. [Google Scholar]
- Al-Hussainy, A.D.L. Evaluation of the Antimicrobial (Antibacterial and Antifungal) Activity of Ethanolic Extracts of Some Medical Plants. J. Nat. Sci. Res. 2015, 5, 87–95. [Google Scholar]
- Sindhusha, V.B.; Rajasekar, A. Preparation and Evaluation of Antimicrobial Property and Anti-Inflammatory Activity of Fenugreek Gel Against Oral Microbes: An Invitro Study. Cureus 2023, 15, e47659. [Google Scholar] [CrossRef]
- Omezzine, F.; Bouaziz, M.; Daami-Remadi, M.; Simmonds, M.S.J.; Haouala, R. Chemical Composition and Antifungal Activity of Trigonella foenum-graecum L. Varied with Plant Ploidy Level and Developmental Stage. Arab. J. Chem. 2017, 10, S3622–S3631. [Google Scholar] [CrossRef]
- CLSI M38M51S; Performance Standards for Antifungal Susceptibility Testing of Filamentous Fungi. Clinical and Laboratory Standards Institute: Wayne, PA, USA, 2022; pp. 1–18.
- Dharajiya, D.; Patel, P.; Patel, M.; Moitra, N. In Vitro Antimicrobial Activity and Qualitative Phytochemical Analysis of Withania Somnifera (L.) Dunal Extracts. Int. J. Pharm. Sci. Rev. Res. 2014, 27, 349–354. [Google Scholar]
- Javed, S.; Shoaib, A.; Mahmood, Z.; Mushtaq, S.; Iftikhar, S. Analysis of Phytochemical Constituents of Eucalyptus citriodora L. Responsible for Antifungal Activity against Post-Harvest Fungi. Nat. Prod. Res. 2012, 26, 1732–1736. [Google Scholar] [CrossRef] [PubMed]

| Parameter | Trigonella foenum-graecum Extract |
|---|---|
| TFC—Rutin mg/L | 3.9517 ± 0.007 * |
| TPC—caffeic acid mg/L | 36.817 ± 0.65 * |
| Compound | Chemical Formula | (m/z) Measured | (m/z) Generated |
|---|---|---|---|
| Diosgenin | C27H42O3 | 415.32089 | 415.32067 |
| Trigonelline | C7H7O2 | 138.05504 | 138.05495 |
| Tigogenin | C27H44O3 | 4.7.33657 | 417.33632 |
| Yamogenin | C27H42O3 | 415.32089 | 415.32067 |
| Vitexin | C21H20O10 | 433.11315 | 433.11292 |
| Acid salicylic | C7H6O3 | 139.03901 | 139.03897 |
| Apigenin 6-C-galactoside 8-C—arabinoside | C26H28O14 | 565.11543 | 565.11518 |
| Luteoline-7-O-glucoside | C21H18O12 | 463.08932 | 463.08710 |
| Apigenin-7-O-glucoside | C21H20O10 | 433.11315 | 433.11292 |
| Protodiosgenin | C51H84O22 | 1049.55408 | 1049.55270 |
| Acid abscisic | C15H20O4 | 265.14352 | 265.14344 |
| Rutin | C27H30O16 | 611.16110 | 611.16066 |
| t-Resveratrol | C14H12O3 | 228.07554 | 228.07810 |
| Parameter | Trigonella foenum-graecum Seed Extract |
|---|---|
| Total reducing sugar (mg D-glucose/mL) | 19.20 ± 0.35 * |
| Total soluble proteins (mg BSA/mL) | 1.96 ± 0.07 * |
| Parameter | Volume of Extract Required to Reduce the Level of Reactive Species with 50% (μL) |
|---|---|
| DPPH | 2.934 ± 0.023 * |
| ABTS | 3.011 ± 0.013 * |
| FRAP | 5.29 ± 0.34 * |
| CUPRAC | 11.64 ± 0.64 * |
| Sample Name | % Sample | Control | |||
|---|---|---|---|---|---|
| 0.10 | 0.50 | 1.00 | 1.50 | ||
| Fenugreek seed extract conditioned in 40% ethanol | 91.67 ± 0.57 * RSD = 3.14 | 91.67 ± 2.08 * RSD = 11.35 | 88.33 ± 2.51 * RSD = 14.54 | 85 ± 0.66 * RSD = 5.88 | 96.67 ± 1.15 * RSD = 5.97 |
| 40% Ethanol (solvent) | 91.66 ± 2.09 * RSD = 11.35 | 81.66 ± 2.51 * RSD =15.40 | 73.33 ± 1.52 * RSD = 10.41 | 90 ± 2.47 * RSD = 11.11 | 93.33 ± 1.15 * RSD = 6.18 |
| Sample Mean | % Sample | Control | |||
|---|---|---|---|---|---|
| 0.10 | 0.50 | 1.00 | 1.50 | ||
| Fenugreek seed extract conditioned in 40% ethanol | 94.8 ** | 94.82 ** | 91.37 ** | 87.93 ** | 96.67 ± 1.15 RSD = 5.97 |
| 40% Ethanol (solvent) | 98.21 | 87.5 | 78.57 | 96.42 | 93.33 ± 1.15 RSD = 6.18 |
| Sample Name | % Sample | Control | |||
|---|---|---|---|---|---|
| 0.10 | 0.50 | 1.00 | 1.50 | ||
| Fenugreek seed extract conditioned in 40% ethanol | + 64.29% (1.19 ± 0.20 RSD = 17.24) | 85.70% (1.58 ± 0.56 RSD = 35.43) | + 50.00 (0.92 ± 0.14 RSD = 15.20) | +;++ 35.79% (0.66 ± 0.14 RSD = 22.11) | * 1.85 ± 0.17 RSD = 9.22 |
| 40% Ethanol (solvent) | 70.48% (1.6 ± 0.47 RSD = 29.81) | 91.18% (2.07 ± 0.23 RSD = 11.13) | 84.87% (1.92 ± 0.71 RSD = 36.93) | 109.10% (2.47 ± 0.47 RSD = 19.31) | 2.27 ± 0.36 RSD = 16.08 |
| Concentrations (mg/mL) | Extract | Aspergillus niger | Fusarium graminearum | Monilinia laxa |
|---|---|---|---|---|
| Inhibition Percentage (%) | Inhibition Percentage (%) | Inhibition Percentage (%) | ||
| 500 | Fenugreek seed extract conditioned in 40% ethanol | 78.01 ± 5.61 | 84.43 ± 4.29 | 66.23 ± 5.55 |
| 40% ethanol (solvent) | 87.32 ± 5.74 | 64.56 ± 5.88 | 57.05 ± 1.99 | |
| p value | <0.05 | <0.05 | <0.05 | |
| 250 | Fenugreek seed extract conditioned in 40% ethanol | 61.78 ± 3.72 | 47.21 ± 0.66 | 45.37 ± 5.41 |
| 40% ethanol | 66.24 ± 0.41 | 0.00 ± 0.00 | 33.64 ± 10.59 | |
| p value | <0.05 | <0.05 | <0.05 | |
| 125 | Fenugreek seed extract conditioned in 40% ethanol | 37.80 ± 1.54 | 44.82 ± 3.63 | 28.78 ± 2.63 |
| 40% ethanol | 32.50 ± 3.72 | 0.00 ± 0.00 | 16.87 ± 3.33 | |
| p value | <0.05 | <0.05 | <0.05 | |
| 62.5 | Fenugreek seed extract conditioned in 40% ethanol | 22.62 ± 3.11 | 28.77 ± 0.51 | 20.19 ± 6.80 |
| 40% ethanol | 25.30 ± 1.46 | 0.00 ± 0.00 | 13.08 ± 5.45 | |
| p value | <0.05 | <0.05 | <0.05 |
Disclaimer/Publisher’s Note: The statements, opinions and data contained in all publications are solely those of the individual author(s) and contributor(s) and not of MDPI and/or the editor(s). MDPI and/or the editor(s) disclaim responsibility for any injury to people or property resulting from any ideas, methods, instructions or products referred to in the content. |
© 2025 by the authors. Licensee MDPI, Basel, Switzerland. This article is an open access article distributed under the terms and conditions of the Creative Commons Attribution (CC BY) license (https://creativecommons.org/licenses/by/4.0/).
Share and Cite
Cristea, S.; Perisoara, A.; Tihauan, B.-M.; Ene, M.D.; Constantin, M.; Florea, A.-M.; Ivan, E.Ş.; Zala, R.C.; Purcăreanu, B.; Mihaiescu, D.E.; et al. In Vitro Evaluation of the Antifungal Activity of Trigonella foenum-graecum Seed Extract and Its Potential Application in Plant Protection. Plants 2025, 14, 3320. https://doi.org/10.3390/plants14213320
Cristea S, Perisoara A, Tihauan B-M, Ene MD, Constantin M, Florea A-M, Ivan EŞ, Zala RC, Purcăreanu B, Mihaiescu DE, et al. In Vitro Evaluation of the Antifungal Activity of Trigonella foenum-graecum Seed Extract and Its Potential Application in Plant Protection. Plants. 2025; 14(21):3320. https://doi.org/10.3390/plants14213320
Chicago/Turabian StyleCristea, Stelica, Alina Perisoara, Bianca-Maria Tihauan, Manuela Diana Ene, Mariana Constantin, Alexandru-Mihai Florea, Elena Ştefania Ivan, Relu Cristinel Zala, Bogdan Purcăreanu, Dan Eduard Mihaiescu, and et al. 2025. "In Vitro Evaluation of the Antifungal Activity of Trigonella foenum-graecum Seed Extract and Its Potential Application in Plant Protection" Plants 14, no. 21: 3320. https://doi.org/10.3390/plants14213320
APA StyleCristea, S., Perisoara, A., Tihauan, B.-M., Ene, M. D., Constantin, M., Florea, A.-M., Ivan, E. Ş., Zala, R. C., Purcăreanu, B., Mihaiescu, D. E., & Pirvu, L. (2025). In Vitro Evaluation of the Antifungal Activity of Trigonella foenum-graecum Seed Extract and Its Potential Application in Plant Protection. Plants, 14(21), 3320. https://doi.org/10.3390/plants14213320

